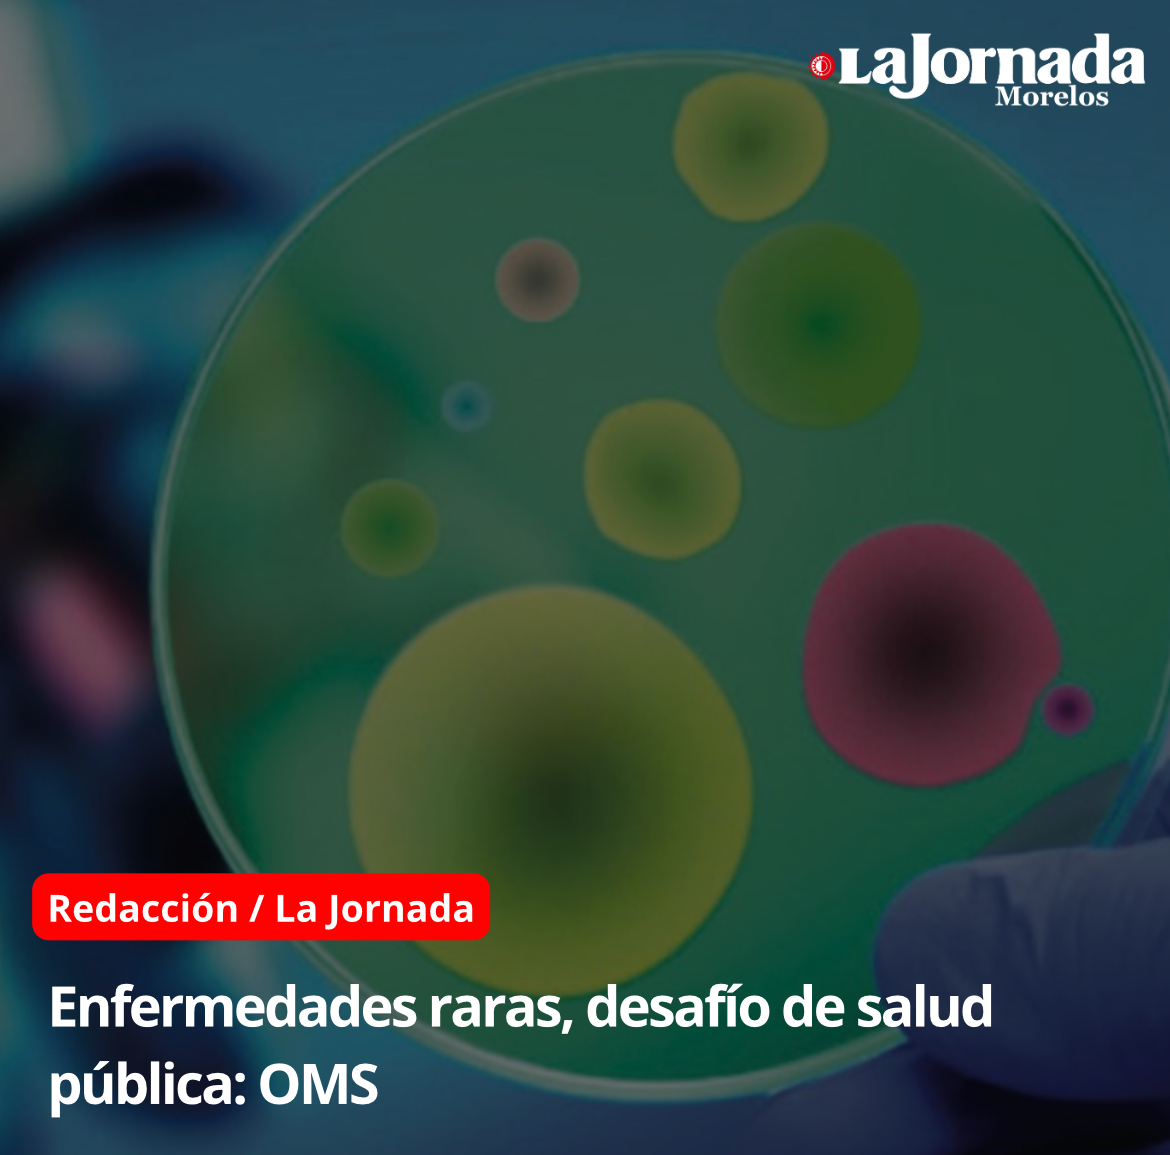

Se invertirá en obras consensuadas con los pueblos indígenas
Al encabezar el Primer Encuentro Estatal Pluricultural Indígena y Afromexicano, la gobernadora, Margarita González Saravia puntualizó que en Morelos se respeta y valora la riqueza de los pueblos y comunidades…